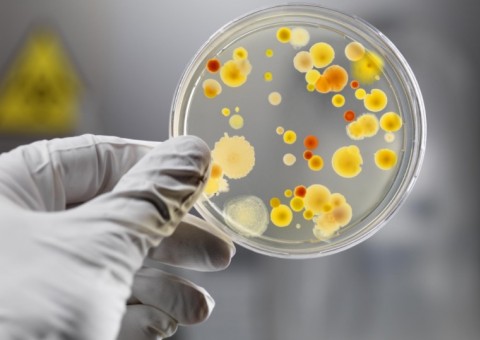
Conheça 3 antibióticos naturais capazes de prevenir e combater infecções bacterianas

Manaus/AM- Ainda que o gosto seja meio amargo, ao contrário da polpa da fruta, o chá da Folha de Mamão papaia é considerado um excelente remédio contra câncer e outras doenças.
Estudos feitos no Japão sugerem a eficácia dessas folhas contra câncer de cólon, próstata, fígado, mama e pulmão. Elas têm duas vezes mais propriedades terapêuticas que o próprio fruto.
Elas contém ação antioxidante, ajudam a prevenir e tratar a úlcera gástrica e estresse oxidativo no estômago. E a enzima chamada papaína, que auxilia a digestão de proteínas, é muito benéfico para o tratamento de distúrbios gastrointestinais.
O chá de folhas do Mamão ajuda a digerir a proteína do glúten do trigo, o que é importante para as pessoas portadoras da doença celíaca. Além disso, este chá ajuda a reduzir desconfortos como azia e má digestão.
É indicado também contra a dengue, pois estimula a produção de novas plaquetas e para desintoxicar o fígado.
Para preparar o chá, use cinco colheres de sopa das folhas secas de Mamão para um litro de água. Deixe ferver por 10 minutos e consuma depois de esfriar.

Aviso